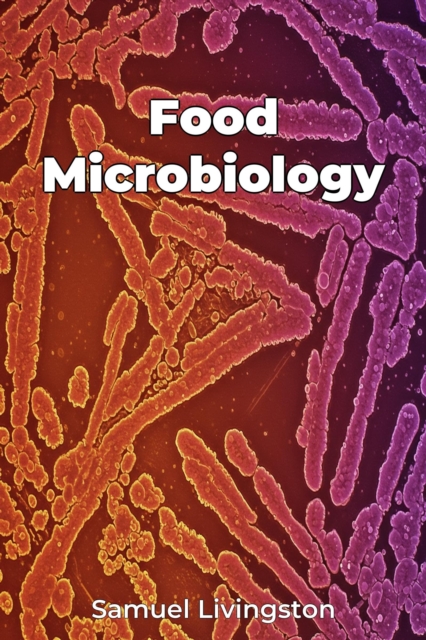
Food Microbiology

Food Microbiology
Food Microbiology explores the crucial role of microorganisms in our food supply, from ensuring food safety to driving fermentation processes. The book examines how bacteria, yeasts, and molds impact food, delving into microbial growth, metabolism, and genetics. It highlights the importance of understanding these microorganisms to prevent foodborne illnesses, which affect millions annually, and to...
Food Microbiology explores the crucial role of microorganisms in our food supply, from ensuring food safety to driving fermentation processes. The book examines how bacteria, yeasts, and molds impact food, delving into microbial growth, metabolism, and genetics. It highlights the importance of understanding these microorganisms to prevent foodborne illnesses, which affect millions annually, and to...
